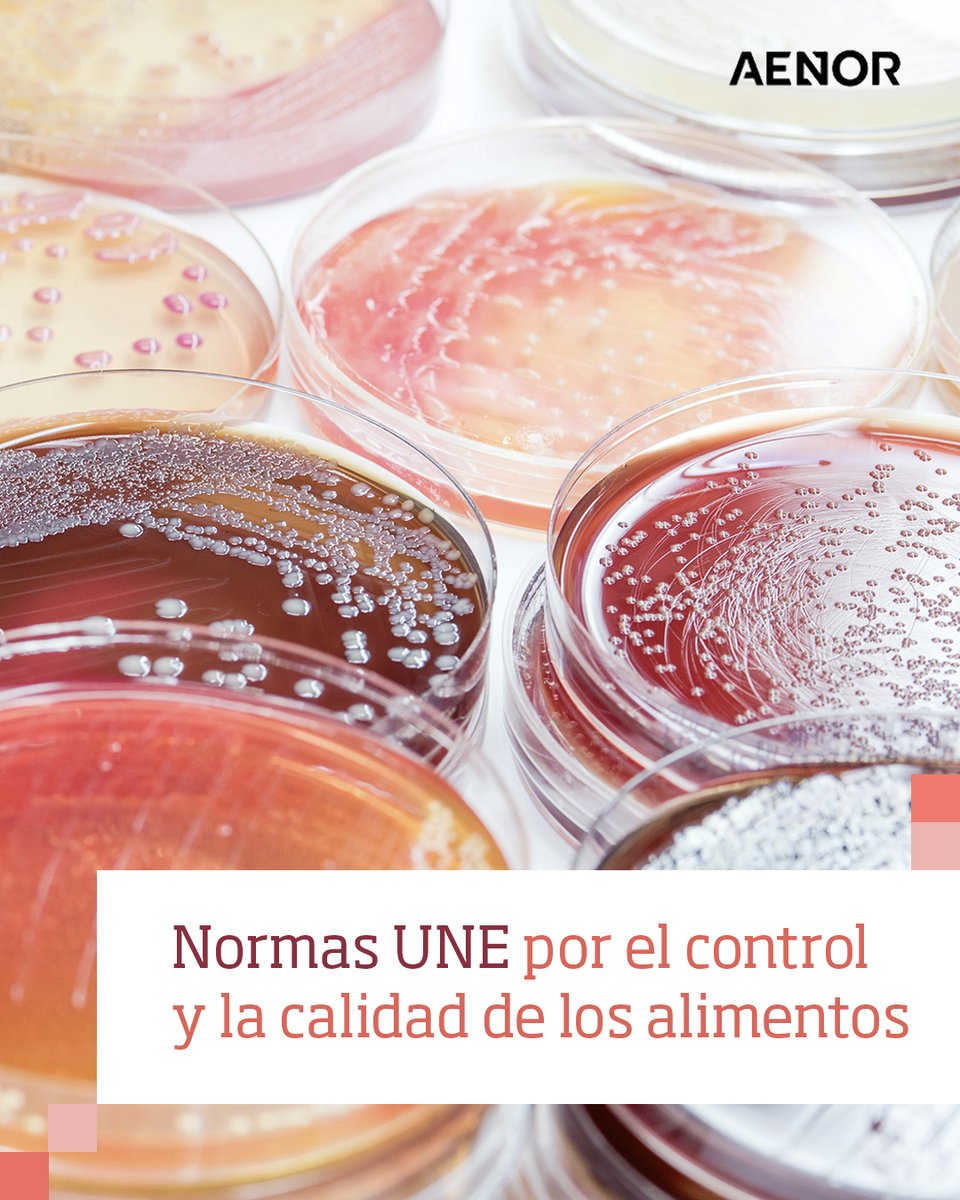
AENOR tweet media

🎥 ¿Te interesa trabajar en Sistemas Integrados de Gestión?
Descubre en este webinar de AENOR Conocimiento:
✔️ Empleabilidad del sector
✔️ Perfiles más demandados
✔️ Oportunidades profesionales
✔️ Valor de las normas ISO
📥 Accede aquí: tr.ee/1CYjEm
#AENORConocimiento #CampusAENOR
Español